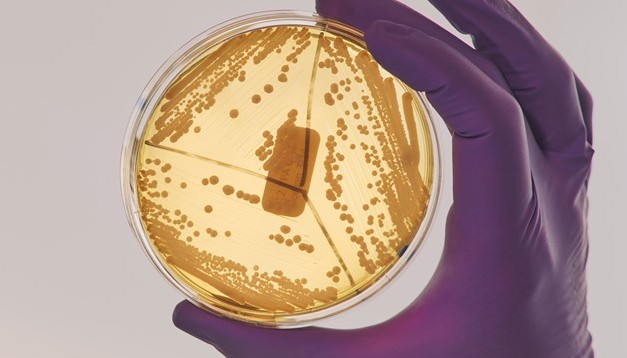
image

利用生物技术的力量,能够提供高性能产品,展现最好的皮肤状态,且对环境友好。
5月9日至11日,在美国时装行业报WWD(《女装日报》,Womens'Wear Daily)于美国迈阿密举行的2022 WWD Beauty CEO峰会上,三大美国生物技术公司高管,Arcaea首席执行官兼创始人Jasmina Aganovic、Amyris首席执行官John Melo和K18首席执行官兼联合创始人Suveen Sahib共同出席,并讨论了生物技术对美容护肤产业日益增长的影响。
在论坛中,他们提及了生物技术可以如何让产业发展更好。Jasmina Aganovic表示,“通过生物技术,我们无需再提取动植物中的成分,而是可以通过发酵获得,这样的方式有很多好处,不仅更可持续、更精确,而且创造了更多的可能性。”也正因此,生物技术的应用从医药、食品领域扩张至美妆护肤领域,并致力于为产业带来更大的可能性。

法国女性杂志Marie Claire英国版资深美容编辑Fiona Embleton解释,“生物技术(Biotech)是生物学与化学相结合的技术,现已走出医学领域并不断进军各大产业。在美妆护肤领域,由生物技术制造的护肤成分通常来源于细菌、酵母和藻类,通过合成、发酵技术,这些细胞得以生长和繁殖。”全球性时尚潮流趋势预测机构Fashion Snoops的趋势预测分析师Mallory Huron补充称,为了获得更多的原材料,基因编辑技术也已经开始应用于美妆护肤领域。
生物合成发酵是产业中应用较为广泛的生物技术之一。致力于减少化妆品对环境影响的非营利组织All Earthlings创始人Sarah Jay介绍称,“生物合成发酵是一个步骤繁杂、由酶进行催化的过程”,在这个过程中,原材料会通过合成、分解、发酵、繁殖生长过程转化为更复杂的成分。
在正常情况下,角鲨烷是从深海鲨鱼肝脏中提取的角鲨烯,经氢化过程制得的烃类油脂,因其亲肤性特别好、且具有保湿润肤功效,经常被用于制作保湿类护肤品。为了获得这种成分往往需要捕杀大量鲨鱼,而现在,包括美国生物技术公司Amyris在内的企业已经利用甘蔗作为原材料,使用合成技术加独特酵母菌株发酵,生成甘蔗角鲨烷,其特性与天然角鲨烷近乎一致,堪称其完美的替代品。

生物合成发酵技术不止用于“复制”传统动植物中的成分,据美国专注于美容的女性杂志Allure特约编辑Jessica Chia介绍,维生素C、维生素A、肽等物质也经常在生物技术的帮助下进行发酵,从而产生视黄醇、抗坏血酸等可以改善皮肤状态的成分。
此外,基因编辑技术是一种更高效的生产所需成分的方式,且其对动植物及自然资源的依赖性更低。爱尔兰生物技术公司ERS Genomics副总裁Jon Kratochvil称,该技术可以在高度精确的位置抑制、激活生物体内的现有基因或插入新基因,从而扭转分子原有的代谢方式甚至是创造全新的代谢方式,产生新物质。
Jasmina Aganovic表示,其所在的美国生物技术公司Arcaea正在进行相关研究,“以斑马鱼为例,斑马鱼的鱼鳞上有丰富的UVA、UVB紫外线过滤器,可以添加入护肤产品中实现防晒功能,但是为了获得所需成分进行猎杀是不道德、不可取的”,因此Arcaea正在尝试获取斑马鱼的DNA,通过读取其中与UVA、UVB紫外线过滤器相关的代码,然后将其复制到以酵母为原材料的分子中,尝试创造新的防晒成分。

当某些护肤所需成分从天然中不易得到时,实验室也会通过生物培养方式来获取所需原料。芦荟苔藓是较为稀有的物种,该种植物提取物加入护肤品中时,有保湿和抗衰老的功能。为了将其持续的应用于产品中,瑞士生物化学企业Mibelle Biochemistry在实验室环境培养了MossCellTec Aloe成分,以此代替从天然芦荟苔藓中可获得的提取物。Mibelle Biochemistry创始人Fred Zülli表示,在生物反应器中培育植物的方式“为化妆品行业带来了新的技术”。
正如Jasmina Aganovic所言,过去的个人护理产品建立在化学基础上,人类从植物、动物中获取生产原材料,然后通过化学过程加工成护肤产品;而现在,“从生物学出发(制造护肤产品)会带来全新的可能性”。
以生物技术为基础的护肤品初创企业Tiny Associates创始人David Koo Hjalmarsson认为,生物技术驱动的护肤品不仅是一个新的品类,更是未来可持续美妆产业的必需品。他指出,“与从植物或石油工业中获取相同的成分相比,生物技术的引入减少了化妆品工业化生产对环境的影响”,在整个生产过程中,其对水、土地、动植物等资源的消耗都会更低。
红没药醇用于护肤品中有镇静肌肤之用,传统中这种原料从洋甘菊或者巴西Candeia树中获取。种植一颗Candeia树需要12年,一吨植物材料中也仅可提取7公斤红没药醇。据英国工程与技术类杂志Engineering and Technology Magazine撰稿人Sarah Griffiths介绍,当使用可持续甘蔗作为原材料,并采用生物技术获取相同的红没药醇时,其所需的农业用地相较Candeia树可以减少30倍,灌溉所需的水资源也显著减少,仅种植环节节约的自然资源就非常可观。

非营利组织All Earthlings创始人Sarah Jay也认为,生物技术为护肤产业提供了“最直接、最有效的原材料,且杜绝了农业、渔业等带来的对资源的破坏性影响......同时也减少了异地获取原材料而产生的碳足迹”。据美国生物技术公司Amyris估计,使用甘蔗角鲨烷代替天然角鲨烷制作护肤品时,每年可以拯救200万条鲨鱼。
生物技术的另一优势在于成分的标准化与供应的稳定性。主打生物科技的护肤品公司Codex Beauty Labs创始人Barbara Paldus表示,当供应商使用不同条件下、不同地区生长的原材料时,其得到的成分往往会参差不齐,因此需要通过混合提取物以保证产品中成分的统一性,而“借助生物技术可以保证成分在受控环境中生长,生产出具备高度一致性、纯度相同的成分”。

另外,自然资源与气候变化息息相关,在恶劣天气下,作物的收成往往会受影响,且原材料也会变得“物以稀为贵”,但是生物实验室制作的成分完全不会受气候变化影响,更不会出现大幅度的价格波动。
美国皮肤病专家Joshua Zeichner称,“在许多方面,生物技术产物优于自然进化提供的产物”。生物技术带来的产品往往具有更大的可能性。Barbara Paldus指出,从植物中提取成分会出现其中所含活性物质浓度不高的情况,而“在生物反应器中,当使用细胞培养物进行培育时,其护肤活性物质浓度相较天然提取物可以高出100倍”。

日本美妆集团资生堂(Shiseido)英国地区培训总监Julia Stewart提供了非常直观的案例,“我们研制出的最新的生物透明质酸可以溶于水和油之中,这意味着它能更好地渗透油性皮肤并被更好地吸收”。Jasmina Aganovic也相信,利用微生物的适应性、自我复制和修复能力,未来通过生物技术可以实现的功能还有很多,比如洗发水可以让头发变直变卷、防晒霜可以根据人体的实际状况生成相吻合的味道等等。

正如美国科学护肤品牌Biossance总裁Catherine Gore所言,“通过利用生物技术的力量,我们能够提供高性能产品,展现最好的皮肤状态,并且不会对环境产生负面影响。” 但是生物技术也有其普及困境,荷兰皇家帝斯曼集团(DSM Nutritional Products) 全球皮肤护理品市场主管、药学博士Mathias Gempeler称,大众对基因改造的疑虑以及投资技术的高昂花销,都是目前阻碍其推进的因素。
